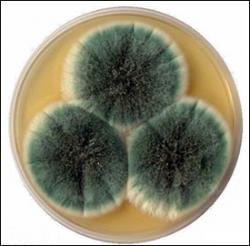

Wat was je in je vorig leven
wat was jij? doe de test!
Mogelijke uitkomsten

Lelijke zwerver (10 x uitgekomen)
Je bent gewoon een lelijke zwerver.
Kan je niets aan doen. jammer.

Lampenkap (11 x uitgekomen)
Tja... blijkbaar vond jij dat lampenkappen de nieuwe mode zouden worden volgend jaar...

Schoenzool (0 x uitgekomen)
Schoenzool, ja, jij bent echt anti-slip!
Schimmel (0 x uitgekomen)
Je bent een schimmel! dat zijn er niet veel man(doeg)

Schoenveter (0 x uitgekomen)
Schoenveters zijn echt in de mode hoor.

Niets (58 x uitgekomen)
je bent gewoon hopeloos(cool)
Statistieken
Meld je gratis aan om ook reacties te kunnen plaatsen
Wat wil je nu doen?
Reageer (13)
Niets.
1 decennium geledenklopt.
Al had ik graag geruild met degene die een zwerver waren.
Dope shit, dude.
Niets
1 decennium geledenlampenkap
1 decennium geledenhelemaal niets!
1 decennium geledenhaha niets:P
1 decennium geleden